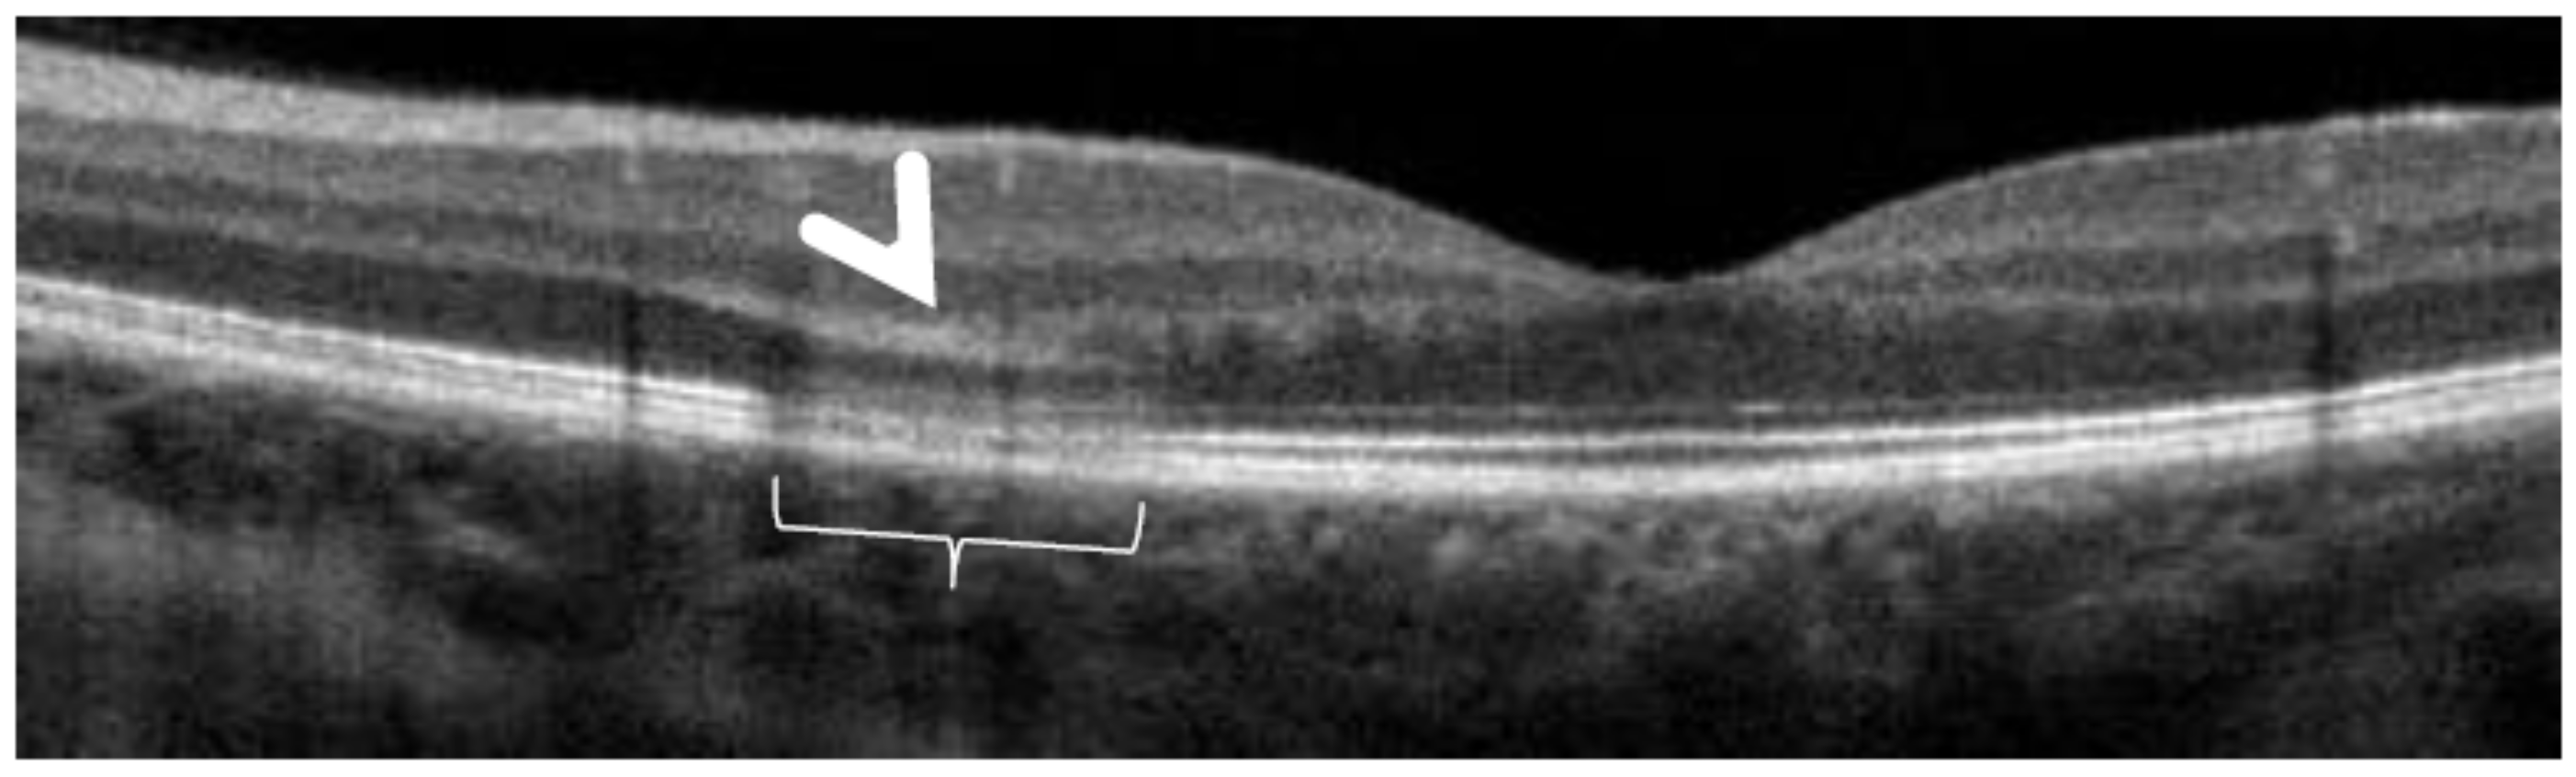
Diagnostics 11 00939 g030

Figure 1.
Difference between fluorescein (FA) and indocyanine green angiography (ICGA). FA is only able to analyse the fluorescence coming from the retina as the retinal pigmentary epithelium is blocking visible light fluorescence (yellow arrow), while ICGA is able to analyse retinal and choroidal near-infrared fluorescence (green arrow).
Figure 1.
Difference between fluorescein (FA) and indocyanine green angiography (ICGA). FA is only able to analyse the fluorescence coming from the retina as the retinal pigmentary epithelium is blocking visible light fluorescence (yellow arrow), while ICGA is able to analyse retinal and choroidal near-infrared fluorescence (green arrow).
Figure 2.
Indocyanine green angiography (ICGA). The ICG-protein complex remains intravascular in retinal vessels rendered impermeable by tight-junctions and in the large choroidal vessels but extrudes freely from the fenestrated choriocapillaris and impregnates progressively the choroidal stroma. It is these intermediate and late angiographic phases that are important for the evaluation of choroiditis.
Figure 2.
Indocyanine green angiography (ICGA). The ICG-protein complex remains intravascular in retinal vessels rendered impermeable by tight-junctions and in the large choroidal vessels but extrudes freely from the fenestrated choriocapillaris and impregnates progressively the choroidal stroma. It is these intermediate and late angiographic phases that are important for the evaluation of choroiditis.
Figure 3.
Indocyanine green angiography (ICGA) patterns in non-infectious choroiditis. Two main patterns have been identified in choroiditis. Pattern 1 is seen in inflammatory choriocapillaris non-perfusion (A). Pattern 2 is found in stromal inflammation when foci develop and impair the diffusion of the ICG-protein complex shedding from the fenestrate choriocapillaris (B). The ICG-protein complex is shown in the insert, which is much larger than the fluorescein molecule with a slow wash-out from the choroid.
Figure 3.
Indocyanine green angiography (ICGA) patterns in non-infectious choroiditis. Two main patterns have been identified in choroiditis. Pattern 1 is seen in inflammatory choriocapillaris non-perfusion (A). Pattern 2 is found in stromal inflammation when foci develop and impair the diffusion of the ICG-protein complex shedding from the fenestrate choriocapillaris (B). The ICG-protein complex is shown in the insert, which is much larger than the fluorescein molecule with a slow wash-out from the choroid.
Figure 4.
Indocyanine green angiography (ICGA), type 1 pattern: choriocapillaris non-perfusion. Typical geographic areas of dark non-fluorescence in case of acute posterior multifocal placoid pigment epitheliopathy or acute multifocal ischaemic choriocapillaritis (APMPPE/AMIC).
Figure 4.
Indocyanine green angiography (ICGA), type 1 pattern: choriocapillaris non-perfusion. Typical geographic areas of dark non-fluorescence in case of acute posterior multifocal placoid pigment epitheliopathy or acute multifocal ischaemic choriocapillaritis (APMPPE/AMIC).
Figure 5.
Indocyanine green angiography (ICGA), type 2 pattern found in stromal choroiditis. Typical round HDDs of similar size, evenly distributed caused by the presence of inflammatory foci that impair the diffusion of the ICG dye showing granulomas in negative in case of Vogt-Koyanagi-Harada disease (VKH).
Figure 5.
Indocyanine green angiography (ICGA), type 2 pattern found in stromal choroiditis. Typical round HDDs of similar size, evenly distributed caused by the presence of inflammatory foci that impair the diffusion of the ICG dye showing granulomas in negative in case of Vogt-Koyanagi-Harada disease (VKH).
Figure 6.
Indocyanine green angiography (ICGA), type 2 pattern found in stromal choroiditis. (A): Typical round HDDs of similar size evenly distributed caused by the presence of inflammatory foci that impair the diffusion of the ICG dye showing granulomas in negative in case of Vogt-Koyanagi-Harada (VKH) disease. Choroidal vessels are no more distinct and appear fuzzy with diffuse hyperfluorescence hiding the HDDs. (B): After three days of intravenous corticosteroids, the choroidal vessels are again distinctly visible, and HDDs have partially resolved.
Figure 6.
Indocyanine green angiography (ICGA), type 2 pattern found in stromal choroiditis. (A): Typical round HDDs of similar size evenly distributed caused by the presence of inflammatory foci that impair the diffusion of the ICG dye showing granulomas in negative in case of Vogt-Koyanagi-Harada (VKH) disease. Choroidal vessels are no more distinct and appear fuzzy with diffuse hyperfluorescence hiding the HDDs. (B): After three days of intravenous corticosteroids, the choroidal vessels are again distinctly visible, and HDDs have partially resolved.
Figure 7.
Multimodal imaging of a case of MEWDS. FA (a) shows faint FA hyperfluorescence probably caused by outer retinal ischaemia. ICGA (b) shows extensive zones of hypofluorescence due to choriocapillaris non-perfusion. FAF (c) shows extensive BAF hyperautofluorescence that co-localise with ICGA hypofluorescent areas and is produced by the loss of the photopigment screen unmasking the normal underlying RPE autofluorescence.
Figure 7.
Multimodal imaging of a case of MEWDS. FA (a) shows faint FA hyperfluorescence probably caused by outer retinal ischaemia. ICGA (b) shows extensive zones of hypofluorescence due to choriocapillaris non-perfusion. FAF (c) shows extensive BAF hyperautofluorescence that co-localise with ICGA hypofluorescent areas and is produced by the loss of the photopigment screen unmasking the normal underlying RPE autofluorescence.
Figure 8.
SD-OCT in a case of MEWDS. Loss of ellipsoid zone (photoreceptor outer segments (arrows) corresponding to the area where BAF hyperautofluorescence and ICGA hypofluorescence are maximal.
Figure 8.
SD-OCT in a case of MEWDS. Loss of ellipsoid zone (photoreceptor outer segments (arrows) corresponding to the area where BAF hyperautofluorescence and ICGA hypofluorescence are maximal.
Figure 9.
Numerous bilateral discolored plaques in a case of APMPPE/AMIC typical bilateral posterior disposition of placoid lesions.
Figure 9.
Numerous bilateral discolored plaques in a case of APMPPE/AMIC typical bilateral posterior disposition of placoid lesions.
Figure 10.
APMPPE/AMIC. Geographic areas of ICGA hypofluorescence.
Figure 10.
APMPPE/AMIC. Geographic areas of ICGA hypofluorescence.
Figure 11.
Case of APMPPE/AMIC. Areas of fundus discoloration due to pooling of fluid under the retina (a). FA shows pooling of liquid under the retina (b). ICGA shows choroidal non-perfusion (c).
Figure 11.
Case of APMPPE/AMIC. Areas of fundus discoloration due to pooling of fluid under the retina (a). FA shows pooling of liquid under the retina (b). ICGA shows choroidal non-perfusion (c).
Figure 12.
Case of APMPPE/AMIC: explanation of FA pooling (FA, left column, ICGA, right column) Choroidal (choriocapillaris) non-perfusion causes retinal ischaemia with retinal vessel increased permeability causing leakage and pooling under the retina. Early frames (a,d), mid-phase (b,e) and late phase (c,f).
Figure 12.
Case of APMPPE/AMIC: explanation of FA pooling (FA, left column, ICGA, right column) Choroidal (choriocapillaris) non-perfusion causes retinal ischaemia with retinal vessel increased permeability causing leakage and pooling under the retina. Early frames (a,d), mid-phase (b,e) and late phase (c,f).
Figure 13.
Idiopathic Multifocal choroiditis (MFC), fundus image. Multiple yellow foci typically seen in MFC (healed stage).
Figure 13.
Idiopathic Multifocal choroiditis (MFC), fundus image. Multiple yellow foci typically seen in MFC (healed stage).
Figure 14.
MFC. ICGA time sequence. (a): shows quiet stage. Middle picture (b) shows reactivation of MFC eight months later. (c): shows healed stage of choriocapillaritis six months later after systemic corticosteroid therapy.
Figure 14.
MFC. ICGA time sequence. (a): shows quiet stage. Middle picture (b) shows reactivation of MFC eight months later. (c): shows healed stage of choriocapillaritis six months later after systemic corticosteroid therapy.
Figure 15.
Vast areas of ICGA hypofluorescence indicating choriocapillaris hypo or nonperfusion surrounding the disc. These areas indicate that in some cases, the inflammatory process going on sub-clinically is involving vast areas of choriocapillaris perfusion problems and can be a trigger for the development of CNVs.
Figure 15.
Vast areas of ICGA hypofluorescence indicating choriocapillaris hypo or nonperfusion surrounding the disc. These areas indicate that in some cases, the inflammatory process going on sub-clinically is involving vast areas of choriocapillaris perfusion problems and can be a trigger for the development of CNVs.
Figure 16.
MFC. Parallel time sequence of ICGA (a,c,e) and FA (b,d,f) during recurrence. Top pair (a,b) show early ICGA and FA frames, showing extended hypofluorescent area on ICGA, while FA is practically normal. Middle pair (c,d) of images show intermediate phase of ICGA and FA (about 10 min) with more extended and well-visible zones of hypofluorescent choriocapillaris nonperfusion on ICGA, while FA shows leakage and staining. Bottom images (e,f) corresponding to late ICGA hypofluorescent areas causing retinal ischaemia and reactional retinal vessel hyperpermeability following the same mechanism as in APMPPE/AMIC.
Figure 16.
MFC. Parallel time sequence of ICGA (a,c,e) and FA (b,d,f) during recurrence. Top pair (a,b) show early ICGA and FA frames, showing extended hypofluorescent area on ICGA, while FA is practically normal. Middle pair (c,d) of images show intermediate phase of ICGA and FA (about 10 min) with more extended and well-visible zones of hypofluorescent choriocapillaris nonperfusion on ICGA, while FA shows leakage and staining. Bottom images (e,f) corresponding to late ICGA hypofluorescent areas causing retinal ischaemia and reactional retinal vessel hyperpermeability following the same mechanism as in APMPPE/AMIC.
Figure 17.
Correlation between FA, ICGA, and visual field during corticosteroid treatment of MFC. This myopic patient presented with left eye photopsias, left decrease of visual acuity (VA) and the presence of a subjective left scotoma. FA (a) only shows cicatricial FA lesions corresponding to cicatricial fundus lesions seen on fundus examination. ICGA (b) shows widespread hypofluorescent areas, indicating fresh choriocapillaris lesions with corresponding visual field defects (c). During corticosteroid therapy, practically no change is seen on FA (d,g), whereas ICGA signs of active disease progressively resolve (e,h) together with visual field improvement (f,i).
Figure 17.
Correlation between FA, ICGA, and visual field during corticosteroid treatment of MFC. This myopic patient presented with left eye photopsias, left decrease of visual acuity (VA) and the presence of a subjective left scotoma. FA (a) only shows cicatricial FA lesions corresponding to cicatricial fundus lesions seen on fundus examination. ICGA (b) shows widespread hypofluorescent areas, indicating fresh choriocapillaris lesions with corresponding visual field defects (c). During corticosteroid therapy, practically no change is seen on FA (d,g), whereas ICGA signs of active disease progressively resolve (e,h) together with visual field improvement (f,i).
Figure 18.
Fundus pictures of MFC showing retinochoroidal scars at the end of a recurrent episode followed by FA (
Figure 19) ICGA (
Figure 20) and by FAF (
Figure 21).
Figure 18.
Fundus pictures of MFC showing retinochoroidal scars at the end of a recurrent episode followed by FA (
Figure 19) ICGA (
Figure 20) and by FAF (
Figure 21).
Figure 19.
FA pictures of MFC at presentation (a), after 1 month (b) and 4 months (c). Patchy hyperfluorescent areas are seen at presentation around optic disc and along temporal superior arcade, indicating staining of retina caused by ischaemia of outer retina (a), still present at 1 month (b), almost resolved after 4 months (c).
Figure 19.
FA pictures of MFC at presentation (a), after 1 month (b) and 4 months (c). Patchy hyperfluorescent areas are seen at presentation around optic disc and along temporal superior arcade, indicating staining of retina caused by ischaemia of outer retina (a), still present at 1 month (b), almost resolved after 4 months (c).
Figure 20.
ICGA pictures of MFC at presentation (a), after 1 month (b) and 4 months (c). Peripapillary confluent hypofluorescence and scattered hypofluorescent areas along superior temporal arcade at presentation (a), which almost completely resolved after one month (b). However, at 4 months, (c) hypofluorescent areas are still seen.
Figure 20.
ICGA pictures of MFC at presentation (a), after 1 month (b) and 4 months (c). Peripapillary confluent hypofluorescence and scattered hypofluorescent areas along superior temporal arcade at presentation (a), which almost completely resolved after one month (b). However, at 4 months, (c) hypofluorescent areas are still seen.
Figure 21.
BAF pictures of MFC at presentation (a), after 1 month (b), and 4 months (c). On the right column of pictures (left eye), hyperautofluorescent areas corresponding to the FA and ICGA lesions can be seen at presentation (a) which, on the (b), have slightly progressed at one month with return to almost normal autofluorescence after 4 months (c). BAF delineates lesions even with more precision than ICGA.
Figure 21.
BAF pictures of MFC at presentation (a), after 1 month (b), and 4 months (c). On the right column of pictures (left eye), hyperautofluorescent areas corresponding to the FA and ICGA lesions can be seen at presentation (a) which, on the (b), have slightly progressed at one month with return to almost normal autofluorescence after 4 months (c). BAF delineates lesions even with more precision than ICGA.
Figure 22.
OCT scans of MFC at presentation through ICGA hypofluorescent area (a), at the border of ICGA hypofluorescent area (b,c). The top set of figures (a) represents a scan going through the ICGA hypofluorescent area (FAF hyperautofluorescent) showing damaged photoreceptor outer segments with clumps throughout the whole scan. (b,c) show scans at the border of the ICGA hypofluorescent (FAF hyperautofluorescent) area with only sectorial damage to the photoreceptor outer segments (arrows) and almost normal ellipsoid zone on the most distant scan from ICGA hypofluorescent (FAF hyperautofluorescent) area.
Figure 22.
OCT scans of MFC at presentation through ICGA hypofluorescent area (a), at the border of ICGA hypofluorescent area (b,c). The top set of figures (a) represents a scan going through the ICGA hypofluorescent area (FAF hyperautofluorescent) showing damaged photoreceptor outer segments with clumps throughout the whole scan. (b,c) show scans at the border of the ICGA hypofluorescent (FAF hyperautofluorescent) area with only sectorial damage to the photoreceptor outer segments (arrows) and almost normal ellipsoid zone on the most distant scan from ICGA hypofluorescent (FAF hyperautofluorescent) area.
Figure 23.
SC: serpiginous lesions on fundus photography. Bilateral creeping lesions typical of SC.
Figure 23.
SC: serpiginous lesions on fundus photography. Bilateral creeping lesions typical of SC.
Figure 24.
SC: comparison of FA and ICGA features in progressing disease. FA (left) shows hyperfluorescent areas resulting from window effect produced by atrophic chorioretinal areas (yellow arrows). ICGA (right) shows that atrophy ± active areas of disease is far more extended than supposed on FA (crimson arrows). Moreover, ICGA shows perilesional hyperfluorescence, indicating the progression of lesions (black arrows). Yellow arrows on FA show occult active areas revealed by ICGA.
Figure 24.
SC: comparison of FA and ICGA features in progressing disease. FA (left) shows hyperfluorescent areas resulting from window effect produced by atrophic chorioretinal areas (yellow arrows). ICGA (right) shows that atrophy ± active areas of disease is far more extended than supposed on FA (crimson arrows). Moreover, ICGA shows perilesional hyperfluorescence, indicating the progression of lesions (black arrows). Yellow arrows on FA show occult active areas revealed by ICGA.
Figure 25.
Serpiginous choroiditis—parallel images of intermediate phase ICGA (left column), late phase ICGA (middle column) and 6 × 6 mm OCT-Angiography (right column) of the right eye. (A). ICGA of the right eye reveals macular hypofluorescent lesions, increasing six months later (B), not responding to a Sub-Tenon’s injection (C), finally responding to the introduction of cyclosporine (D). (OCT-A pictures evolve in parallel with ICGA frames with faint dark areas visible at presentation ((A), right), more clearly visible 6 months later ((B), right) and three months after sub-Tenon’s injection ((C), right) and disappearing three months after cyclosporine treatment (D).
Figure 25.
Serpiginous choroiditis—parallel images of intermediate phase ICGA (left column), late phase ICGA (middle column) and 6 × 6 mm OCT-Angiography (right column) of the right eye. (A). ICGA of the right eye reveals macular hypofluorescent lesions, increasing six months later (B), not responding to a Sub-Tenon’s injection (C), finally responding to the introduction of cyclosporine (D). (OCT-A pictures evolve in parallel with ICGA frames with faint dark areas visible at presentation ((A), right), more clearly visible 6 months later ((B), right) and three months after sub-Tenon’s injection ((C), right) and disappearing three months after cyclosporine treatment (D).
Figure 26.
Case of Amppiginous Choroiditis. Disease started as APMPPE/AMIC lesions but progressed to become confluent resembling more serpiginous choroiditis. Extensive scarring was also more characteristic of SC.
Figure 26.
Case of Amppiginous Choroiditis. Disease started as APMPPE/AMIC lesions but progressed to become confluent resembling more serpiginous choroiditis. Extensive scarring was also more characteristic of SC.
Figure 27.
Clinicopathology hypothesis for the PICCPs. Type and extent of vascular involvement determine the clinical picture.
Figure 27.
Clinicopathology hypothesis for the PICCPs. Type and extent of vascular involvement determine the clinical picture.
Figure 28.
ASPPC (Acute Syphilitic Posterior Placoid Choroiditis) Posterior placoid lesion (a), hyperautofluorescent (FAF, (b)) due to loss of photoreceptor outer segments (OCT—(c)) and better visualization lipofuscin in RPE. On FA, the placoid lesion is hyperfluorescent due to ischaemia of outer retina because of choriocapillaris non-perfusion appearing hypofluorescent on ICGA (d,e). SD-OCT (c) shows loss of photoreceptor outer segments (yellow arrows) corresponding to visual field loss (insert c-top). On the lower post-treatment SD-OCT, outer segments reconstitute with improvement of visual field (insert, c-bottom).
Figure 28.
ASPPC (Acute Syphilitic Posterior Placoid Choroiditis) Posterior placoid lesion (a), hyperautofluorescent (FAF, (b)) due to loss of photoreceptor outer segments (OCT—(c)) and better visualization lipofuscin in RPE. On FA, the placoid lesion is hyperfluorescent due to ischaemia of outer retina because of choriocapillaris non-perfusion appearing hypofluorescent on ICGA (d,e). SD-OCT (c) shows loss of photoreceptor outer segments (yellow arrows) corresponding to visual field loss (insert c-top). On the lower post-treatment SD-OCT, outer segments reconstitute with improvement of visual field (insert, c-bottom).
Figure 29.
AMN. Fundus appearance. Petaloid lesion.
Figure 29.
AMN. Fundus appearance. Petaloid lesion.
Figure 30.
AMN. SD-OCT image performed one day after the onset of symptoms. SD-OCT shows a highly reflective band at the level of the OPL/ONL (arrowhead), resembling Paracentral Acute Middle Maculopathy (PAMM) with alterations of EZ and IZ lines (bracket).
Figure 30.
AMN. SD-OCT image performed one day after the onset of symptoms. SD-OCT shows a highly reflective band at the level of the OPL/ONL (arrowhead), resembling Paracentral Acute Middle Maculopathy (PAMM) with alterations of EZ and IZ lines (bracket).
Figure 31.
AMN. NIR-R, SD-OCT and FAF images at eight days after the onset of symptoms. (a): NIR-R imaging shows a sharply oval hyporeflective area (arrows) corresponding, on SD-OCT (b), to an attenuation of the EZ whereas the IZ is not seen (b, bracket). (c): BAF signal is normal.
Figure 31.
AMN. NIR-R, SD-OCT and FAF images at eight days after the onset of symptoms. (a): NIR-R imaging shows a sharply oval hyporeflective area (arrows) corresponding, on SD-OCT (b), to an attenuation of the EZ whereas the IZ is not seen (b, bracket). (c): BAF signal is normal.
Figure 32.
AMN. NIR-R, SD-OCT, FAF, FA, and ICGA images at first presentation. NIR-R and SD-OCT images: NIR-R imaging shows hyporeflective petal-like oval areas in the macular region (arrows) in corresponding on SD-OCT to a reduction of the signal of the IZ (brackets). In OD, the reduction of the signal is limited to two segments of the outer retina, while in OS, it comprises the whole outer retinal section corresponding to the hyporeflective infrared lesion.
Figure 32.
AMN. NIR-R, SD-OCT, FAF, FA, and ICGA images at first presentation. NIR-R and SD-OCT images: NIR-R imaging shows hyporeflective petal-like oval areas in the macular region (arrows) in corresponding on SD-OCT to a reduction of the signal of the IZ (brackets). In OD, the reduction of the signal is limited to two segments of the outer retina, while in OS, it comprises the whole outer retinal section corresponding to the hyporeflective infrared lesion.
Figure 33.
Case of UIAM at presentation: (a) fundus photography showing a reddish foveal detachment surrounded with an irregular, circular area of greyish RPE discoloration. (b) BL-FAF shows a light hypoautofluorescence in the macular area. (c,d) FA early and late phases reveal late hyperfluorescence due to the leakage and pooling in the neurosensory foveal detachment. (e,f) ICGA early and late phases reveal persistent hypofluorescent area surrounded, in the late frame, by a hyperfluorescent ring, sign of hyperpermeability of the choroidal vessels.
Figure 33.
Case of UIAM at presentation: (a) fundus photography showing a reddish foveal detachment surrounded with an irregular, circular area of greyish RPE discoloration. (b) BL-FAF shows a light hypoautofluorescence in the macular area. (c,d) FA early and late phases reveal late hyperfluorescence due to the leakage and pooling in the neurosensory foveal detachment. (e,f) ICGA early and late phases reveal persistent hypofluorescent area surrounded, in the late frame, by a hyperfluorescent ring, sign of hyperpermeability of the choroidal vessels.
Figure 34.
UAIM. EDI-OCT findings from one day after symptom onset to one year later. (a) at presentation, a neurosensory dome-shaped foveal (bacillary layer) detachment with compartmentalized subretinal turbid fluid and a choroidal thickening beneath the fovea. (b) a week later, complete resolution of the foveal detachment, damage of the outer retina with the loss of the ellipsoid zone and reduction of the choroidal thickness. (c) three weeks later, the outer retinal boundary is less irregular and the choroidal thickness is reduced. (d) two months later, further reorganization of outer retinal structures without the visualization of the ellipsoid zone. (e) one year later, there is an almost complete normalization of the outer retina with the recovery of the ellipsoid zone and interdigitation zone (black arrows). The choroidal thickness (green cursor) remains low compared to onset of the disease.
Figure 34.
UAIM. EDI-OCT findings from one day after symptom onset to one year later. (a) at presentation, a neurosensory dome-shaped foveal (bacillary layer) detachment with compartmentalized subretinal turbid fluid and a choroidal thickening beneath the fovea. (b) a week later, complete resolution of the foveal detachment, damage of the outer retina with the loss of the ellipsoid zone and reduction of the choroidal thickness. (c) three weeks later, the outer retinal boundary is less irregular and the choroidal thickness is reduced. (d) two months later, further reorganization of outer retinal structures without the visualization of the ellipsoid zone. (e) one year later, there is an almost complete normalization of the outer retina with the recovery of the ellipsoid zone and interdigitation zone (black arrows). The choroidal thickness (green cursor) remains low compared to onset of the disease.
Figure 35.
Images of a case of UIAM a week after the onset of symptoms. (a) fundus photography showing well-circumscribed area of RPE atrophy and hyperplasia. (b,c) BAF and NIR-FAF show stippled hyperautofluorescence, more evident in NIR mode, indicating increase not only of lipofuscin but especially of melanin and compounds closely related to melanin. (d) FA in the late phase shows hyperfluorescence (staining). (e,f) ICGA early and late phases reveal only in the late phase of the angiography a large area of hypofluorescent dark area, sign of choriocapillaris ischaemic non-perfusion.
Figure 35.
Images of a case of UIAM a week after the onset of symptoms. (a) fundus photography showing well-circumscribed area of RPE atrophy and hyperplasia. (b,c) BAF and NIR-FAF show stippled hyperautofluorescence, more evident in NIR mode, indicating increase not only of lipofuscin but especially of melanin and compounds closely related to melanin. (d) FA in the late phase shows hyperfluorescence (staining). (e,f) ICGA early and late phases reveal only in the late phase of the angiography a large area of hypofluorescent dark area, sign of choriocapillaris ischaemic non-perfusion.
Figure 36.
AZOOR. Fundus photograph showing a pale ring around the fovea OD (arrows) (a) and normal OS (b). In (c) Fundus autofluorescence (FAF) shows an extensive C-shaped hyperautofluorescent area around the fovea with dots of hypoautofluoresce within this zone OD. (FAF OD 1) Left hyperautofluorescence parapapillary inferiorly and supero-temporally to the fovea. (FAF OS 1), corresponding to the loss of photoreceptors on SD OCT, extensive in OD (brackets in OCT OD 1 (d)), with a stable evolution after infliximab therapy (FAFOD/OS 2 and brackets in OCT OD 2 (d)).
Figure 36.
AZOOR. Fundus photograph showing a pale ring around the fovea OD (arrows) (a) and normal OS (b). In (c) Fundus autofluorescence (FAF) shows an extensive C-shaped hyperautofluorescent area around the fovea with dots of hypoautofluoresce within this zone OD. (FAF OD 1) Left hyperautofluorescence parapapillary inferiorly and supero-temporally to the fovea. (FAF OS 1), corresponding to the loss of photoreceptors on SD OCT, extensive in OD (brackets in OCT OD 1 (d)), with a stable evolution after infliximab therapy (FAFOD/OS 2 and brackets in OCT OD 2 (d)).
Figure 37.
AZOOR. FA faint hyperfluorescence corresponding to the C-shaped hyperautofluorescent area on FAF OD ((a), FA OD 1), including a zone inside this area of brighter hyperfluorescence (window defect), indicating chorioretinal atrophy. (a, FA OD 1). In the periphery on the right panorama supero-temporal vasculitis ((b), FA OD 1, (arrows)). Late ICGA frames show hyperfluorescence corresponding to the C-shaped hyperautofluorescent areas on FAF, indicating preservation of choriocapillaris, except in the area along the superior temporal arcade, which was hypofluorescent corresponding to hypoautofluorescence on FAF and hyperfluorescence on FA, all images indicating chorioretinal atrophy (ICGA OD 1, (c), and ICGA OD 1, (d)). Images remained stable after infliximab therapy (a FA OD 2 and c, ICGA OD 2).
Figure 37.
AZOOR. FA faint hyperfluorescence corresponding to the C-shaped hyperautofluorescent area on FAF OD ((a), FA OD 1), including a zone inside this area of brighter hyperfluorescence (window defect), indicating chorioretinal atrophy. (a, FA OD 1). In the periphery on the right panorama supero-temporal vasculitis ((b), FA OD 1, (arrows)). Late ICGA frames show hyperfluorescence corresponding to the C-shaped hyperautofluorescent areas on FAF, indicating preservation of choriocapillaris, except in the area along the superior temporal arcade, which was hypofluorescent corresponding to hypoautofluorescence on FAF and hyperfluorescence on FA, all images indicating chorioretinal atrophy (ICGA OD 1, (c), and ICGA OD 1, (d)). Images remained stable after infliximab therapy (a FA OD 2 and c, ICGA OD 2).
Figure 38.
Cartoon of choroidal lesion and the analogic concept of iceberg effect.
Figure 38.
Cartoon of choroidal lesion and the analogic concept of iceberg effect.
Figure 39.
Retinal and vitreous involvement in BRC. Large strands of vitreous opacities and widespread retinal vasculitis.
Figure 39.
Retinal and vitreous involvement in BRC. Large strands of vitreous opacities and widespread retinal vasculitis.
Figure 40.
Choroidal involvement in BRC. Typical rice-shaped discolored areas.
Figure 40.
Choroidal involvement in BRC. Typical rice-shaped discolored areas.
Figure 41.
ICGA in BRC. Even round HDDs regularly distributed over all the fundus.
Figure 41.
ICGA in BRC. Even round HDDs regularly distributed over all the fundus.
Figure 42.
Pseudo-delay in retinal circulation. A patient in the exudative stage of BRC exhibits no fluorescein marking of large veins at 42.3 s. (a) and 47.4 s (b) after injection. This is not due to an increase of arterio-venous circulation time, but to massive extrusion of the small fluorescein molecule from retinal capillaries and larger vessels. This phenomenon is revealed by ICGA; opacification of large veins occurs normally at 24.0 s (c), as the large ICG complex does not extrude from retinal vessels.
Figure 42.
Pseudo-delay in retinal circulation. A patient in the exudative stage of BRC exhibits no fluorescein marking of large veins at 42.3 s. (a) and 47.4 s (b) after injection. This is not due to an increase of arterio-venous circulation time, but to massive extrusion of the small fluorescein molecule from retinal capillaries and larger vessels. This phenomenon is revealed by ICGA; opacification of large veins occurs normally at 24.0 s (c), as the large ICG complex does not extrude from retinal vessels.
Figure 43.
Foveal sparing of diffuse retinal edema. This patient was followed for more than seven years for “neuroretinitis”, without treatment. There is massive retinal oedema that also involves the posterior pole, yet the fovea remains relatively spared, which explains the patient’s preserved visual acuity, while visual fields were severely impaired (
Figure 44).
Figure 43.
Foveal sparing of diffuse retinal edema. This patient was followed for more than seven years for “neuroretinitis”, without treatment. There is massive retinal oedema that also involves the posterior pole, yet the fovea remains relatively spared, which explains the patient’s preserved visual acuity, while visual fields were severely impaired (
Figure 44).
Figure 44.
Visual field impairment due to diffuse retinal oedema of posterior pole while fovea is spared. Explains why BRC patients retain a full visual acuity while visual fields are severely impaired.
Figure 44.
Visual field impairment due to diffuse retinal oedema of posterior pole while fovea is spared. Explains why BRC patients retain a full visual acuity while visual fields are severely impaired.
Figure 45.
Progression of retinal disease as followed by optical coherence tomography (x axis indicates distance from fovea (=0); y axis indicates thickness of retina in microns). Early disease (green line) features thickening of the retina (and to a lesser degree, the fovea). In late disease (yellow line), there is diffuse thinning, except in the fovea; foveal thickness remains comparable to normal (purple line) (from Ophthalmic Surg Lasers Imaging 2012; 43-suppl S25–31).
Figure 45.
Progression of retinal disease as followed by optical coherence tomography (x axis indicates distance from fovea (=0); y axis indicates thickness of retina in microns). Early disease (green line) features thickening of the retina (and to a lesser degree, the fovea). In late disease (yellow line), there is diffuse thinning, except in the fovea; foveal thickness remains comparable to normal (purple line) (from Ophthalmic Surg Lasers Imaging 2012; 43-suppl S25–31).
Figure 46.
ICGA lesions. Fundus examination is best to monitor disease activity (right eye). This patient accepted treatment with delay with numerous hypopigmented birdshot lesions. After applying immunosuppressive therapy, the HDDs, numerous before treatment (b) responded to treatment (d), while no fundus change was seen (a,c), as birdshot fundus lesions correspond to stromal scars.
Figure 46.
ICGA lesions. Fundus examination is best to monitor disease activity (right eye). This patient accepted treatment with delay with numerous hypopigmented birdshot lesions. After applying immunosuppressive therapy, the HDDs, numerous before treatment (b) responded to treatment (d), while no fundus change was seen (a,c), as birdshot fundus lesions correspond to stromal scars.
Figure 47.
VKH exudative retinal detachments. Fundus photograph showing posterior peripapillary and parafoveal temporal inferior exudative retinal detachments.
Figure 47.
VKH exudative retinal detachments. Fundus photograph showing posterior peripapillary and parafoveal temporal inferior exudative retinal detachments.
Figure 48.
VKH exudative retinal detachments. FA showing posterior peripapillary and parafoveolar temporal inferior exudative retinal detachments.
Figure 48.
VKH exudative retinal detachments. FA showing posterior peripapillary and parafoveolar temporal inferior exudative retinal detachments.
Figure 49.
ICGA in VKH disease. Regular distribution all over the fundus of evenly sized HDDs before treatment (a) having mostly disappeared after the introduction of dual steroidal and non-steroidal immunosuppression (b).
Figure 49.
ICGA in VKH disease. Regular distribution all over the fundus of evenly sized HDDs before treatment (a) having mostly disappeared after the introduction of dual steroidal and non-steroidal immunosuppression (b).
Figure 50.
EDI-OCT measuring choroidal thickness in VKH disease. At presentation (a), mean subfoveolar thickness is increased to 502.6 µm. After introduction of steroidal and non-steroidal immunosuppression (b), thickness was reduced to 334.3 µm.
Figure 50.
EDI-OCT measuring choroidal thickness in VKH disease. At presentation (a), mean subfoveolar thickness is increased to 502.6 µm. After introduction of steroidal and non-steroidal immunosuppression (b), thickness was reduced to 334.3 µm.
Figure 51.
Choroiditis in Sarcoidosis. Unevenly sized randomly distributed fundus lesions.
Figure 51.
Choroiditis in Sarcoidosis. Unevenly sized randomly distributed fundus lesions.
Figure 52.
FA and ICGA findings in sarcoidosis chorioretinitis (left eye). FA shows diffuse retinal vasculitis of large and small vessels, papillitis (hyperfluorescent disc), and cystoid macular oedema. ICGA shows HDDs randomly scattered and some areas of fuzzy vessels with most choroidal vessels still well delineated.
Figure 52.
FA and ICGA findings in sarcoidosis chorioretinitis (left eye). FA shows diffuse retinal vasculitis of large and small vessels, papillitis (hyperfluorescent disc), and cystoid macular oedema. ICGA shows HDDs randomly scattered and some areas of fuzzy vessels with most choroidal vessels still well delineated.
Figure 53.
Secondary sarcoid stromal choroiditis. Arterial macroaneurysm (yellow arrows) on fundus photography (a), FA (b), and ICGA (c,d). Note fuzziness of choroidal vessels on ICGA (c,d) and random distribution of hypofluorescent areas (d).
Figure 53.
Secondary sarcoid stromal choroiditis. Arterial macroaneurysm (yellow arrows) on fundus photography (a), FA (b), and ICGA (c,d). Note fuzziness of choroidal vessels on ICGA (c,d) and random distribution of hypofluorescent areas (d).
Table 1.
ICG angiographic signs in stromal choroiditis.
Table 1.
ICG angiographic signs in stromal choroiditis.
| 1. Hypofluorescent dark dots (HDDs) |
| 2. Indistinct choroidal vessel (Fuzziness of choroidal vessels) |
| 3. Diffuse late choroidal hyperfluorescence (partially hiding HDDs) |
| 4. ICGA disc hyperfluorescence (in severe choroiditis) |
Table 2.
Multimodal imaging of MEWDS lesions and clinicopathological explanation.
Table 2.
Multimodal imaging of MEWDS lesions and clinicopathological explanation.
| BAF | Hyperfluorescence (increased exposure of RPE lipofuscin following loss of outer photoreceptor segments) |
| ICGA | Hypofluorescence (intermediate and late phase) (choriocapillaris non-perfusion of endcapillary portions) |
| SD-OCT | Loss of photoreceptor outer segments |
| OCTA | No sign of choriocapillaris drop out (OCTA is incapable to image low-flow endcapillary vessels) |
| FA | Faint hyperfluorescence (possibly due to outer retina ischaemia) |
Table 4.
Multimodal imaging of idiopathic MFC lesions and clinicopathological explanation.
Table 4.
Multimodal imaging of idiopathic MFC lesions and clinicopathological explanation.
| BAF | Hyperautofluorescence (exposure of RPE lipofuscin due to loss of outer segments) (occult lesions in active disease) |
| | Hypoautofluorescence of atrophic lesions due to previous episodes |
| ICGA | Hypofluorescent areas (atrophic areas of previous episodes + active choriocapillaritis (non-perfusion)) of new occult active areas |
| OCT | Loss of photoreceptor outer segments in occult active areas ± chorioretinal atrophic areas; also hyperreflective clumps |
| OCTA | Choriocapillaris drop-out (less sensitive than ICGA); also useful to identify CNV |
| FA | Very early hypofluorescence followed by late hyperfluorescence (full atrophic areas of previous episodes/ window effect) |
| | Active lesions occult, barely visible, faint late hyperfluorescence unless extensive choriocapillaritis |
Table 5.
Global diagnostic criteria for HLA-A29 birdshot retinochoroiditis [
101].
Table 5.
Global diagnostic criteria for HLA-A29 birdshot retinochoroiditis [
101].
| 1. Presence of vitritis in one or both eyes (required) |
| 2. Presence of retinal vasculitis in one or both eyes (required) |
| 3. Stromal choroiditis, as evidenced by ICGA, in both eyes (required) |
| 4. HLA-A29 antigen positivity (required) |
| 5. Visual field anomalies in one or both eyes (supportive) |
| 6. Absence of extra-ocular inflammatory site (supportive) |
| 7. Presence of rice-shaped depigmented “birdshot lesions” (BRC fundus lesions) (strongly supportive but not required) |
Table 6.
Diagnostic criteria for initial onset VKH disease [
121].
Table 6.
Diagnostic criteria for initial onset VKH disease [
121].
| 1. No ocular trauma or surgery preceding onset of disease * |
| 2. Bilateral involvement (verified with ICGA and/or EDI-OCT) * |
| 3. Exclusion of other infectious, inflammatory, or masquerading entities, in particular other stromal choroiditis entities (i.e., tuberculosis, sarcoidosis, or syphilis) * |
| 4. Diffuse choroiditis evidenced by ICGA and/or EDI-OCT * |
| 5. Signs and symptoms of less than four-weeks’ duration * |
| 6. Absence of clinical findings compatible with chronic disease (i.e., sunset glow fundus or integumentary signs (vitiligo, alopecia, and poliosis) * |
| 7. Exudative retinal detachments (evidenced by pooling and pinpoint leaking points on FA and ICGA) (very helpful criterion when present) |
| 8. Disc hyperfluorescence (helpful criterion) |
| 9. Neurological/auditory findings (meningismus, tinnitus, acute hearing loss) (helpful criterion) |
Table 7.
List of IWOS clinical signs suggestive of ocular sarcoidosis [
136].
Table 7.
List of IWOS clinical signs suggestive of ocular sarcoidosis [
136].
| 1. Mutton-fat KPs (large and small) and/or iris nodules at pupillary margin (Koeppe) or in stroma (Busacca) |
| 2. Trabecular meshwork (TM) nodules and/or tent-shaped peripheral anterior synechiae (PAS) |
| 3. Snowballs/string of pearls vitreous opacities. |
| 4. Multiple chorioretinal peripheral lesions (active and atrophic) |
| 5. Nodular and/or segmental peri-phlebitis (± candle-wax drippings) and/or macroaneurysm in an inflamed eye |
| 6. Optic disc nodule(s)/granuloma(s) and/or solitary choroidal nodule |
| 7. Bilaterality (assessed by clinical examination or investigational tests showing subclinical inflammation). |